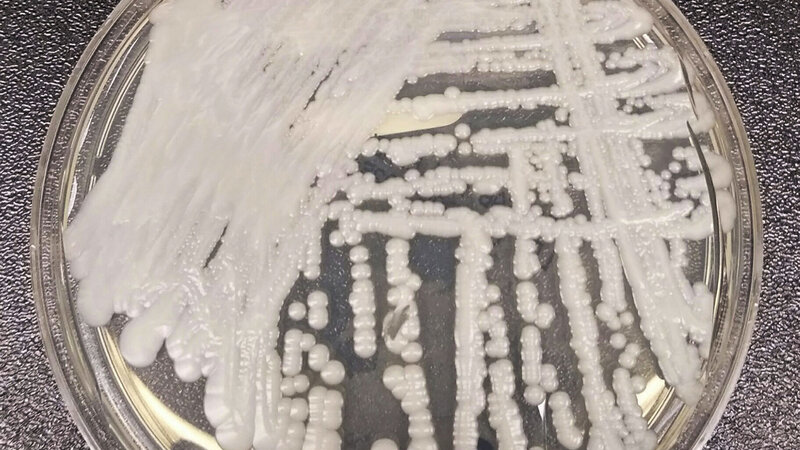

Posted on Mar 21, 2023
The potentially deadly Candida auris fungus is spreading quickly in the U.S.
1.43K
30
6
14
14
0
Posted 3 y ago
Responses: 5
PO1 William "Chip" Nagel good day Brother William, always informational and of the most interesting. Thanks for sharing, have a blessed day!
(6)
(0)
Read This Next

Medical
Medical Health
Health


